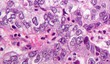
Image

-

31 Dec 2013
Towards a Molecular Explanation for Schizophrenia
by Alen Piljić
- Views 1059
- More stats
-
27 Dec 2013
Systematic, genomic study of cervical cancer completed
- Views 1333
- More stats
-

24 Dec 2013
What Sharks, Honeybees and Humans Have in Common
- Views 6095
- More stats
-

20 Dec 2013
Sardinia Biomed Cluster – A Biomed Kind of Island
by Nazareno Commissari
- Views 1386
- More stats
-

19 Dec 2013
Neandertal genome project completed
- Views 3740
- More stats
-

16 Dec 2013
Chimpanzees are rational, not conformists
by Alen Piljić
- Views 1137
- More stats
-

14 Dec 2013
New catalyst for fuel cells - a potential substitute for platinum
- Views 4199
- More stats
-

09 Dec 2013
How different species age
- Views 1874
- More stats
-

06 Dec 2013
Fractal geometry of cancer cells
- Views 36741
- More stats
-

04 Dec 2013
Microplastics make marine worms sick
by Alen Piljić
- Views 1680
- More stats
Latest News in Life Sciences
Read the latest news, announcements and press releases from life sciences and related disciplines, including news from biotechnology and pharmaceutical research and development. When you join Life Science Network, you can follow your favorite sources to get notified when content matching your interests is published.
You can post a news article here
Join Life Science Network
Join LSN to acces all jobs and fully benefit from the platform and its features.
News module
Are you interested in posting articles on Life Science Network?
Please continue reading here.
For more information about Life Science Network,
contact us at [email protected].
Loading ad...